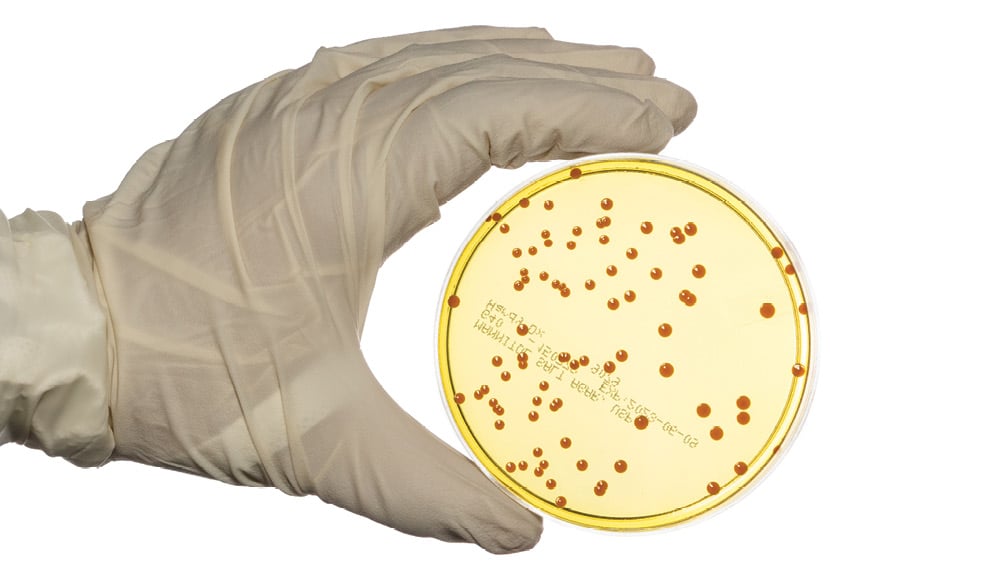

- Show Menu
- Contact Us
- FAQs
- Reader Service
- Survey Data
- Survey Winners
- Testimonials
- Upcoming Events
- Webinars
- White Papers
February 2024


Viable Air and Surface Sampling Course for Sterile Compounding
The Eagleson Institute, a life science training resource, offers a new course on viable air and surface sampling, emphasizing appropriate sampling locations... Read more

Prescription Fulfillment
Capsa Healthcare announces an expansion into high volume/high speed prescription fulfillment operations by leveraging its recent investments in global... Read more

Cold Storage Line
Helmer Scientific announces the completion of the GX Solutions Cold Storage product line expansion with the launch of GX Solutions Ultra Low Temperature... Read more

Chemotherapy Medication Partnership
Long Grove Pharmaceuticals is expanding its product offerings through an in-licensing of cyclophosphamide for injection, USP from Sunny Pharmtech. Cyclophosphamide... Read more

HD Compounding System
Equashield launches the Mundus Mini HD, a compounding solution designed to incorporate safety, quality, and efficiency into the process of automated compounding... Read more

Automation Technologies
Swisslog Healthcare, a provider of pharmacy and transport automation solutions, offers several automation solutions for medication packaging, storage,... Read more
Microbial Growth Identification
Eagle Analytical Services provides solutions for monitoring and controlling microorganisms in controlled environments. Tryptic soy agar (TSA) contact and... Read more

Ultra-Low Temperature Freezer
PHCbi brand VIP ECO series ultra-low temperature chest freezers are made to provide reliable, precise temperatures for safe, long-term storage of high-value... Read more

Admixture Device
The addition of the Vial2Bag Advanced 13mm admixture device from West Pharmaceutical Services complements the existing Vial2Bag Advanced 20mm admixture... Read more

Diversion Prevention System
WasteWitness from PharmID is a comprehensive solution that uses Raman spectroscopy, AI-powered risk assessment, and a real-time dashboard to help organizations... Read more

IV Bag Recycling Pilot
Baxter announces the completion of the first phase of its IV bag recycling program pilot. Launched in conjunction with Northwestern Medicine in Chicago,... Read more

RFID Tagged Medication Compatibility
Health Care Logistics (HCL) and AmerisourceBergen collaborate to enable users of AmerisourceBergen’s RFID tagged products to take advantage... Read more

Drug Diversion Study Results
The State of Drug Diversion 2023 Report from Wolters Kluwer Heath examines drug diversion programs from the view of healthcare executives, pharmacists,... Read more

















